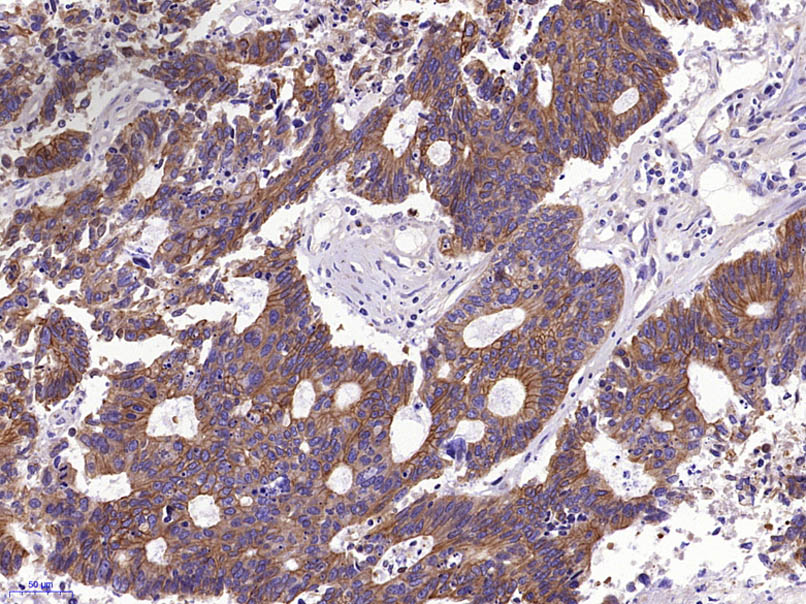
Pan Cytokeratin Rabbit pAb(bs-
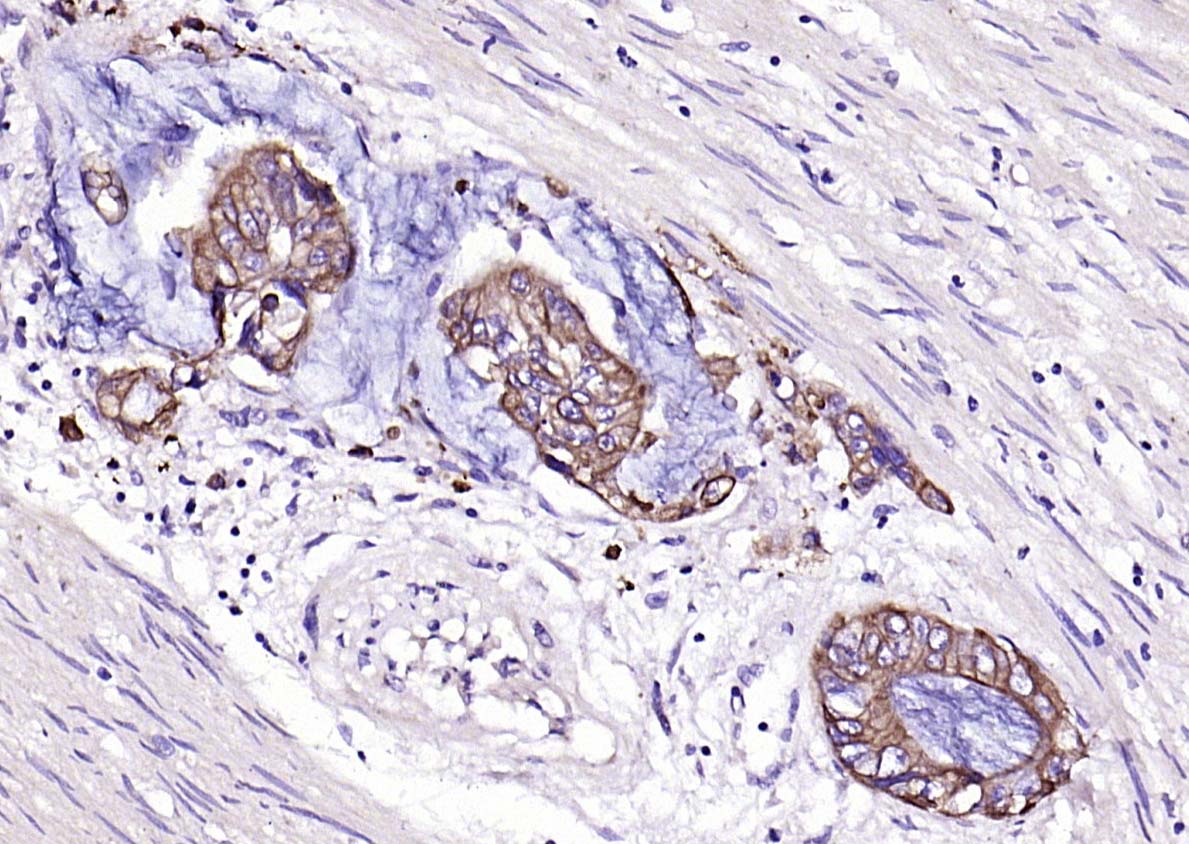
Pan Cytokeratin Rabbit pAb(bs-

相关产品推荐更多 >
万千商家帮你免费找货
0 人在求购买到急需产品
- 详细信息
- 文献和实验
- 技术资料
- 应用范围:
产品信息以Bioss网站为准
- 规格:
50ul/100ul/200ul
| 规格: | 50ul | 产品价格: | ¥1180.0 |
|---|---|---|---|
| 规格: | 100ul | 产品价格: | ¥1980.0 |
| 规格: | 200ul | 产品价格: | ¥2800.0 |
| 产品编号 | bs-1712R |
| 英文名称 | Pan Cytokeratin Rabbit pAb |
| 中文名称 | 广谱细胞角蛋白PCK抗体 |
| 英文别名 | pan-cytokeratin; pan-CK; pan CK; P-CK; CK-PAN; wide spectrum Cytokeratin; Cytokeratins; [cytokeratins 1, 2, 4, 5, 6, 7, 8, 71, 72, 75, 78]. |
| 产品应用 | WB=1:500-2000, IHC-P=1:100-2000, IHC-F=1:100-500, ICC/IF=1:100-500, IF=1:100-500, Flow-Cyt=1μg /test Not yet tested in other applications. |
| 交叉反应 | Human, Mouse, Rat (Chicken, Dog, Pig, Cow, Horse, Rabbit) |
| 抗体来源 | Rabbit |
| 免疫原 | KLH conjugated synthetic peptide derived from human cytokeratins |
| 亚型 | IgG |
| 性状 | Liquid |
| 纯化方法 | affinity purified by Protein A |
| 克隆类型 | Polyclonal |
| 理论分子量 | 42-64 kDa |
| 浓度 | 1mg/ml |
| 储存液 | 0.01M TBS (pH7.4) with 1% BSA, 0.02% Proclin300 and 50% Glycerol. |
| 研究领域 | Signal Transduction > Cytoskeleton / ECM > Cytoskeleton > Intermediate Filaments > Class I > Cytokeratins |
| 亚细胞定位 | Cytoplasmic. |
| 组织特异性 | epithelial cells |
| 保存条件 | Shipped at 4℃. Store at -20℃ for one year. Avoid repeated freeze/thaw cycles. |
| 注意事项 | This product as supplied is intended for research use only, not for use in human, therapeutic or diagnostic applications. |
| 背景资料 | Cytokeratins are proteins of keratin-containing intermediate filaments found in the intracytoplasmic cytoskeleton of epithelial tissue. The cytokeratins are encoded by a family encompassing 30 genes. Among them, 20 are epithelial genes and the remaining 10 are specific for trichocytes. In the cytoplasm, the keratin filaments conform a complex network which extends from the surface of the nucleus to the cell membrane. Numerous accessory proteins are involved in the genesis and maintenance of such structure. This association between the plasma membrane and the nuclear surface provides important implications for the organization of the cytoplasm and cellular communication mechanisms. Apart from the relatively static functions provided in terms of supporting the nucleus and providing tensile strength to the cell, the cytokeratin networks undergo rapid phosphate exchanges mediated depolymerization, with important implications in the more dynamic cellular processes such as mitosis and post-mitotic period, cell movement and differentiation. Cytokeratins interact with desmosomes and hemidesmosomes, thus collaborating to cell-cell adhesion and basal cell-underlying connective tissue connection. |
| 应用 | 推荐稀释比例 |
| {WB} | {1:500-2000} |
| {IHC-P} | {1:100-2000} |
| {IHC-F} | {1:100-500} |
| {ICC/IF} | {1:100-500} |
| {IF} | {1:100-500} |
| {Flow-Cyt} | {1μg /test} |


Primary: Anti-Pan Cytokeratin (bs-1712R) at 1/300 dilution
Secondary: IRDye800CW Goat Anti-Rabbit IgG at 1/20000 dilution
Predicted band size: 42-64 kD
Observed band size: 60 kD

Primary Antibody (green line): Rabbit Anti-Pan Cytokeratin antibody (bs-1712R)
Dilution: 1μg /10^6 cells;
Isotype Control Antibody (orange line): Rabbit IgG .
Secondary Antibody (white blue line): Goat anti-rabbit IgG-PE
Dilution: 1μg /test.
Protocol
The cells were fixed with 70% methanol (Overnight at 4℃) and then permeabilized with 90% ice-cold methanol for 20 min at -20℃. Cells stained with Primary Antibody for 30 min at room temperature. The cells were then incubated in 1 X PBS/2%BSA/10% goat serum to block non-specific protein-protein interactions followed by the antibody for 15 min at room temperature. The secondary antibody used for 40 min at room temperature. Acquisition of 20,000 events was performed.

Lane 1: Hela (Human) Cell Lysate at 30 ug
Lane 2: A549 (Human) Cell Lysate at 30 ug
Lane 3: A673 (Human) Cell Lysate at 30 ug
Primary: Anti-Pan Cytokeratin (bs-1712R) at 1/1000 dilution
Secondary: IRDye800CW Goat Anti-Rabbit IgG at 1/20000 dilution
Predicted band size: 42-64 kD
Observed band size: 46,60 kD

Primary Antibody (green line): Rabbit Anti-Pan Cytokeratin antibody (bs-1712R)
Dilution: 2ug/Test;
Secondary Antibody : Goat anti-rabbit IgG-FITC
Dilution: 0.5ug/Test.
Protocol
The cells were fixed with 4% PFA (10min at room temperature)and then permeabilized with 0.1% PBST for 20 min at room temperature.The cells were then incubated in 5%BSA to block non-specific protein-protein interactions for 30 min at room temperature .Cells stained with Primary Antibody for 30 min at room temperature. The secondary antibody used for 40 min at room temperature. Acquisition of 20,000 events was performed.

Primary Antibody (green line): Rabbit Anti-Pan Cytokeratin antibody (bs-1712R)
Dilution:1ug/Test;
Secondary Antibody(white blue line): Goat anti-rabbit IgG-AF488
Dilution: 0.5ug/Test.
Isotype control(orange line): Normal Rabbit IgG
Protocol
The cells were fixed with 4% PFA (10min at room temperature)and then permeabilized with 90% ice-cold methanol for 20 min at -20℃, The cells were then incubated in 5%BSA to block non-specific protein-protein interactions for 30 min at room temperature .Cells stained with Primary Antibody for 30 min at room temperature. The secondary antibody used for 40 min at room temperature. Acquisition of 20,000 events was performed.
风险提示:丁香通仅作为第三方平台,为商家信息发布提供平台空间。用户咨询产品时请注意保护个人信息及财产安全,合理判断,谨慎选购商品,商家和用户对交易行为负责。对于医疗器械类产品,请先查证核实企业经营资质和医疗器械产品注册证情况。
文献和实验[IF={{ 9.685 }}] {Chen Mingyu. et al. Identification of RAC1 in promoting brain metastasis of lung adenocarcinoma using single-cell transcriptome sequencing. CELL DEATH DIS. 2023 May;14(5):1-14} {IHC} {Mouse}
[IF={{ 9.417 }}] {Yan Wu. et al. A mesenchymal stem cell-derived nanovesicle-biopotentiated bovine serum albumin-bridged gelatin hydrogel for enhanced diabetic wound therapy. MATER DESIGN. 2023 Jun;230:111960} {IHC} {Mouse}
[IF={{ 7.038 }}] {Verdiana Trappetti. et al. Synchrotron Microbeam Radiotherapy for the treatment of lung carcinoma: a pre-clinical study. Int J Radiat Oncol. 2021 Aug;:} {WB} {Rat}
[IF={{ 6.7 }}] {Jian Shi. et al. Mechanistic elucidation of QiJu-DiHuang Wan in management of age-related dry eye through metabolomics and network pharmacology. PHYTOMEDICINE. 2024 Sep;132:155884} {IF} {Rat}
[IF={{ 6.126 }}] {Wakiyama H et al. Increased Immunogenicity of a Minimally Immunogenic Tumor after Cancer-Targeting Near Infrared PhotoimmunotherapyCancers (Basel).2020 Dec 12;12(12):3747.} {IHC} {Mouse}
技术资料暂无技术资料 索取技术资料









